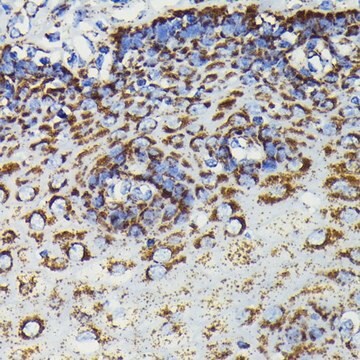
Anti-SOD2 antibody produced in rabbit

Anti-SOD2 antibody produced in rabbit
别名:
Anti-Superoxide dismutase [Mn], mitochondrial precursor antibody produced in rabbit, Anti-IPO-B, Anti-MNSOD, Anti-Superoxide dismutase 2, mitochondrial
Products
产品分类
品牌
生物来源
克隆
基因别名
物质形态
产品线
抗体形式
研究领域
共轭
质量水平
翻译后修饰
物种反应
技术
Showing 1-4 of 4
比较
产品编号
说明
价格